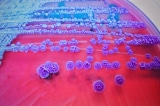
My phat hien loai vi khuan gay chet nguoi trong mau dat va nuoc 1

Tháng 1, 2026
- 22 Tháng 1
Mỹ: Bang Tennessee bùng phát dịch nấm chết người, hàng chục người bị nhiễm
Các quan chức của bang này xác nhận rằng một số bệnh nhân đã được nhập viện, một số người trong số đó đang trong tình trạng nguy kịch.
Tháng 10, 2025
- 13 Tháng 10
Đừng bao giờ dùng chung 3 thứ này trong phòng tắm
Những rủi ro khi sử dụng một số vật dụng như khăn tắm, bàn chải đánh răng hoặc dao cạo râu đã qua sử dụng của người khác là gì?
Tháng 9, 2025
- 5 Tháng 9
10 vật dụng hàng ngày là nơi trú ngụ của vi khuẩn
Miếng bọt biển nhà bếp có lẽ là một trong những vật dụng bẩn nhất trong nhà bạn.
Tháng 5, 2025
- 4 Tháng 5
Lớp phủ kháng khuẩn mới có thể tiêu diệt nhiều loại vi khuẩn ‘cứng đầu’ hàng ngày
Trong cuộc sống hàng ngày, nhiều bề mặt vật thể có thể trở thành nơi trú ẩn của vi khuẩn, đặc biệt trong môi trường y tế
Tháng mười một, 2024
- 24 Tháng mười một
Vi khuẩn đường ruột: Chìa khóa mới trong quản lý căng thẳng
Nghiên cứu được công bố trên tạp chí Cell Metabolism (Chuyển hóa Tế bào) cho thấy, vi khuẩn đường ruột ảnh hưởng đến chu kỳ ngủ-thức và phản ứng căng thẳng.
- 22 Tháng mười một
Nghiên cứu: Kẽm giúp chống lại tình trạng kháng kháng sinh ở vi khuẩn
Các nhà nghiên cứu từ Đại học Tiểu bang Iowa đã phát hiện ra rằng, bổ sung kẽm trong khẩu phần ăn có thể giúp ngăn ngừa vi khuẩn chia sẻ gen kháng kháng sinh…
Tháng 9, 2024
- 20 Tháng 9
Loại vi khuẩn có thể khiến gần 40 triệu người tử vong vào năm 2050
Nghiên cứu của GRAM chỉ ra rằng số ca tử vong do kháng thuốc sẽ tiếp tục gia tăng nếu không có biện pháp khắc phục hiệu quả.
Tháng 5, 2024
- 28 Tháng 5
Hiểu rõ về loại vi khuẩn này có thể giúp bạn ngăn ngừa ngộ độc thực phẩm
Trong những năm gần đây, các vụ ngộ độc thực phẩm do vi khuẩn tụ cầu vàng (Staphylococcus aureus) xảy ra ở mức độ đáng báo động. Theo thống kê của Cục Quản lý Thực…
- 14 Tháng 5
Những sai lầm phổ biến này sẽ biến tủ lạnh thành “kho thuốc độc”
Hội đồng Y tế Toàn cầu đã tiến hành một cuộc khảo sát về vệ sinh hộ gia đình tại 9 quốc gia bao gồm Hoa Kỳ, Canada, Úc và cho biết 46% tủ lạnh…
Tháng 5, 2023
- 26 Tháng 5
Khăn tắm 3 ngày không giặt chứa nhiều vi khuẩn như ở bồn cầu
Nghiên cứu đã chỉ ra rằng nếu khăn tắm không được giặt trong 3 ngày, vi khuẩn sẽ sinh sôi nhiều như ở trong bồn cầu.
Tháng 9, 2022
- 7 Tháng 9
Mẹo làm sạch thảm Yoga để diệt trừ vi khuẩn
Việc tích tụ lâu ngày những chất thải từ mồ hôi và kem dưỡng da là môi trường thuận lợi cho các loại vi khuẩn tiềm ẩn trong thảm yoga.
Tháng 7, 2022
- 29 Tháng 7
Mỹ phát hiện loại vi khuẩn gây chết người trong mẫu đất và nước
Burkholderia pseudomallei là một loại vi khuẩn có khả năng gây chết người, lần đầu được phát hiện trong mẫu đất và nước ở Mỹ.
Tháng 6, 2022
- 24 Tháng 6
Phát hiện loại vi khuẩn lớn nhất thế giới có kích cỡ như lông mi người
Các nhà khoa học mới đây đã phát hiện ra loại vi khuẩn lớn nhất thế giới với hình sợi trắng có kích cỡ như lông mi người, được tìm thấy tại Pháp.
Tháng 10, 2021
- 8 Tháng 10
10 thói quen xấu khiến virus dễ lây lan
Dưới đây là 10 thói quen xấu bạn nên tránh để hạn chế virus lây lan và xâm nhập vào cơ thể.
Tháng 9, 2021
- 29 Tháng 9
CDC Mỹ: Vi khuẩn Salmonella không rõ nguồn gốc lan rộng ra 29 tiểu bang
Một đợt bùng phát vi khuẩn Salmonella trên toàn quốc từ một nguồn bí ẩn hiện đã lây lan ra 29 tiểu bang.
Tháng 10, 2019
- 16 Tháng 10
Xin lỗi ông, Darwin, nhưng vi khuẩn không cạnh tranh để sinh tồn
Vi khuẩn sẽ thích sống một mình hay hợp tác nhóm?
Tháng 6, 2019
- 16 Tháng 6
Vì sao tốt nhất là đừng uống cà phê trên máy bay?
Khi đi máy bay, người ta thường sẽ gọi món ăn hoặc thức uống.
Tháng 4, 2019
- 25 Tháng 4
Nghiên cứu: Râu đàn ông có nhiều vi khuẩn hơn lông chó “đáng kể”
Nhiều người sẽ có thể cảm thấy bị xúc phạm...
Tháng 10, 2018
- 3 Tháng 10
Giải Nobel Vật lý 2018: Hai phát minh quan trọng trong lĩnh vực tia laser
Người phụ nữ thứ 3 nhận giải Nobel Vật lý trong trong lịch sử
Tháng 9, 2018
- 20 Tháng 9
8 “quả bom vi khuẩn” ngay trong nhà bạn
Trong nhà bạn, có những vị trí và đồ dùng nhìn bên ngoài thấy thật sạch sẽ, nhưng kỳ thực chúng lại chứa đầy vi khuẩn và tiềm ẩn nguy cơ khiến bạn mắc bệnh